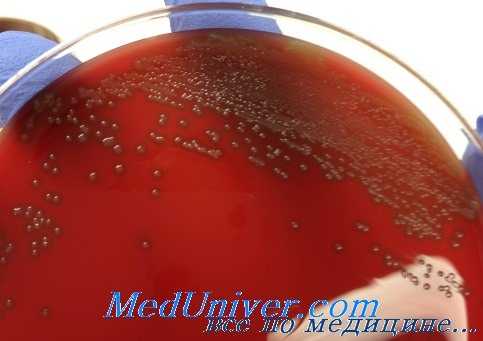
пневмококковая инфекция

Микробиологическая диагностика пневмококка. Диагностика пневмококковой инфекции. Выявление пневмококка. Выделение пневмококка. Лечение пневмококковой инфекции.
Добавил пользователь Владимир З. Обновлено: 08.11.2025
Пневмококковая инфекция обусловлена патогенным микроорганизмом Streptococcus pneumoniae. Этот возбудитель является главной причиной острых внебольничных пневмоний, занимает ведущее место в этиологии бактериальных менингитов, острых средних отитов, синуситов, вызывает первичный сепсис, заболевания кожи, суставов и другие инфекции, пневмококки являются этиологической причиной пневмонии в 20–75% случаев. Риносинусит имеет пневмококковую этиологию в 20–43% случаев, средний отит – 30–50%.
Ежегодно в США диагностируется около 4 млн. случаев внебольничной пневмонии и более 3 млн. в странах Европейского союза. В России число таких больных превышает 1,5 млн. человек в год, а заболеваемость составляет 14–15 случаев на 1000 населения. По данным Министерства обороны РФ у военных срочной службы в течение 2000–2003 гг. заболеваемость пневмонией превышала показатель 40 случаев на 1000 военнослужащих.
Заболеваемость пневмококковым менингитом в США определяется на уровне 1–2 случая на 100 тыс. населения с уровнем летальности 19–46% в различных возрастных группах. В России, по данным Референс-центра по надзору за гнойными бактериальными менингитами за 2010 г., общий уровень заболеваемости составил 0,19 на 100 тыс. населения (с колебаниями по Федеральным округам от 0,11 до 0,30 на 100 тыс. населения), с летальностью 13%.
В тоже время, пневмококк относится к нормальным обитателям ротоглотки и частота здорового носительства в популяции может достигать 40–70%. При этом возможно как одновременное носительство различных серотипов пневмококка, так и смена одного серотипа другим в течение непродолжительного времени. Заболевание пневмонией, отитом, синуситом, как правило, возникает при попадании микроба в нижние или верхние дыхательные пути на фоне нарушения защитных механизмов организма человека (снижение уровня общего и местного иммунитета, нарушение мукоцилиарного клиренса и др.). При генерализации процесса развивается сепсис, менингит, абсцессы внутренних органов, поражения сердца (эндокардит), почек, суставов.
Резервуаром пневмококковой инфекции является человек. Вместе с тем, пневмококковая патология встречается у диких и домашних копытных животных (овец, коз, телят и т. д.), преимущественно в виде пневмонии или сепсиса. Выделенный возбудитель от животных не отличается по свойствам от пневмококка, вызывающего заболевание у людей.
Основной путь передачи инфекции – воздушно-капельный, иногда контактный. Отмечены случаи внутриутробного заражения. Пик заболеваемости приходится на холодные сезоны года и носит спорадический характер. Среди заболевших преобладают мужчины. Наиболее уязвимыми возрастными контингентами являются дети до 5 лет и лица пожилого возраста (старше 65 лет). Пневмококковая инфекция наиболее тяжело, с генерализацией инфекционного процесса, протекает у лиц старших возрастов, особенно при наличии сопутствующих хронических патологий (хроническая обструктивная болезнь легких, злокачественные новообразования, алкоголизм, сахарный диабет, заболевания сердечно-сосудистой системы, почек и печени и др.), а также иммунодефицитов различного генеза.
Показания к обследованию. Пациенты при подозрении на крупозную пневмонию, острый бронхит; отит, синусит; менингит, менингоэнцефалит; септическое состояние; поражения кожи, подкожной клетчатки, соединительной ткани (редкая локализация инфекции); конъюнктивит (редкая локализация инфекции).
Дифференциальная диагностика проводится с микробными агентами:
- при подозрении на внебольничную пневмонию: Haemophilus influenzae, Chlamydia pneumoniae, Mycoplasma pneumoniae, Legionella pneumophila, Staphylococcus aureus, семейством Enterobacteriaceae, вирусами гриппа;
- при отитах, синуситах – Haemophilus influenzae, Pseudomonas aeruginosa, Staphylococcus aureus, Moraxella catarrhalis, Streptococcus pyogenes, дрожжевыми грибами рода Candida;
- при менингите – Neisseria meningitides, Haemophilus influenzae тип b, Staphylococcus aureus, семействомEnterobacteriaceae;
- при поражениях кожи, подкожной клетчатки, соединительной ткани – Streptococcus pyogenes, Staphylococcus aureus, Pseudomonas aeruginosa.
Материал для исследования
- Мокрота, БАЛ, пунктаты (при подозрении на пневмонию); гнойное отделяемое, пунктаты (средний отит, синусит); СМЖ, кровь (менингит, менингоэнцефалит); кровь (септические состояния); отделяемое из раны (кожные поражения); секционный материал – культуральные исследования, выявление ДНК микроорганизма;
- СМЖ – определение АГ;
- сыворотка крови – определение АГ, АТ.
Этиологическая лабораторная диагностика включает выявление пневмококков методом микроскопии, посев исследуемого материала с дальнейшей культуральной и биохимической идентификацией возбудителя, определением антибиотикочувствительности; обнаружение специфических генетических фрагментов пневмококка и его АГ, обнаружение специфических АТ.
Сравнительная характеристика методов лабораторной диагностики и особенности интерпретации их результатов. Микроскопические исследования используют для выявления пневмококков в разных видах биологического материала: мокроте, плевральной жидкости, отделяемом из уха, придаточных пазух, СМЖ, крови. Диагностическая ценность обнаружения в мазке мокроты диплококков «сходных с пневмококками» до сих пор остается дискуссионной. Большинство исследователей считают, что это исследование может использоваться только при соблюдении ряда жестких условий:
- взятие материала должно проводиться до начала антибиотикотерапии;
- контроль правильности отбора, доставки и обработки материала:
- задержка приготовления препарата на 2–5 ч от момента взятия материала может привести к ошибочным результатам;
- подтверждением взятия образца мокроты из нижних отделов дыхательных путей служит выявление менее 10 эпителиальных клеток в поле зрения при малом увеличении микроскопа;
- материал считается пригодным для бактериологического посева при обнаружении в мокроте большого количества нейтрофилов (более 25 в поле зрения), небольшого количества эпителиальных клеток (менее 10 в поле зрения) и преобладании монофлоры, по морфологии сходной с пневмококком.
Для посева с дальнейшей культуральной и биохимической идентификацией возбудителя, определением антибиотикочувствительности используют различные виды материала: мокрота, бронхоальвеолярный лаваж, отделяемое из уха и придаточных пазух, кровь, ликвор, плевральная жидкость.
При наличии роста на чашках проводится обязательная количественная оценка бактериального роста и выделение чистой культуры предполагаемого возбудителя для дальнейшей идентификации.
Принадлежность к виду Streptococcus pneumoniae подтверждается:
- характерным видом колоний на средах, содержащих кровь (колонии по форме напоминают игральные шашки или блюдца, мелкие, прозрачные, окружены зоной зеленоватого гемолиза);
- чувствительностью микроорганизма к оптохину;
- чувствительностью к желчным кислотам;
- положительной реакцией набухания капсулы с антипневмококковой omniсывороткой;
- биохимической характеристикой возбудителя с использованием соответствующих наборов реагентов.
Оценка результатов культурального исследования. Для нестерильных локусов:
- выявление при посеве в мокроте или лаважной жидкости более чем 10 3 КОЕ/мл пневмококков является диагностическим критерием постановки диагноза пневмония;
- выявление в гнойном экссудате при остром бактериальном синусите более 10 5 КОЕ/мл пневмококков является диагностическим критерием постановки диагноза синусит;
- выявление в гнойном отделяемом при остром среднем отите более 10 4 КОЕ/мл пневмококков, является диагностическим критерием постановки диагноза отит.
Для стерильных локусов:
- любое выявление возбудителя в стерильных жидкостях организма служит основанием для постановки диагноза пневмококковой инфекции.
Для определения чувствительности к антибиотикам используются несколько методов.
- Метод серийных разведений в бульоне или агаре. Принцип метода основан на оценке чувствительности возбудителя к серии последовательных разведений тестируемого антибиотика. При этом определяется точное значение минимальной подавляющей концентрации (МПК) препарата для микроорганизма. Однако изза значительной трудоемкости, метод используется преимущественно в научных лабораториях. Более широкое применение получил модифицированный метод серийных разведений, основанный на использовании пограничных концентраций антибиотика, который не дает точного определения МПК препарата для возбудителя, но позволяет оценить его принадлежность к чувствительным (S), промежуточно устойчивым (I) или резистентным (R) штаммам. Большинство готовых наборов реагентов используют именно этот принцип.
- Диско-диффузионный метод – основан на оценке диаметра зоны подавления роста вокруг бумажного диска с антибиотиком, наложенного на растущую на плотной питательной среде культуру исследуемого микроорганизма. Образование зоны ингибирования роста происходит за счет диффузии антибактериального препарата из носителя (диска) в питательную среду, при которой величина диаметра ингибирования роста жестко связана с величиной МПК. Метод не определяет точное значение минимальной подавляющей концентрации антибиотика для микроорганизма, а только позволяет отнести его к одной из категорий чувствительности (S, I, R).
- Метод эпсилометрии (Е-тест) – в качестве носителя используется полоска полимера, пропитанная различными концентрациями антибиотика, с нанесенными на нее значениями таких концентраций. Интерпретации результатов выполняют в соответствии с инструкцией к набору реагентов.
Наиболее важным при тяжелых пневмококковых инфекциях является определение чувствительности пневмококков к пенициллину и другим бета-лактамным антибиотикам (аминопенициллинам, карбапинемам, цефалоспоринам) – основным препаратам выбора. В качестве скринингового теста для определения чувствительности к этим препаратам используется диско-диффузионный метод.
В исследование обязательно включают изучение чувствительности к макролидам, линкозамидам, стрептограминам. Данные препараты часто используются для лечения внегоспитальной пневмококковой пневмонии и заболеваний верхних дыхательных путей. Пневмококки могут быть устойчивыми только к 14- и 15-членным макролидам, при сохранении чувствительности к 16-членным макролидам и линкозамидам, а могут быть устойчивыми ко всем представителям этих классов.
Определение устойчивости к хинолонам, хлорамфениколу, тетрациклину, котримоксазолу, рифампицину, ванкомицину, позволяет более полно характеризовать фенотип возбудителя. При этом необходимо учитывать, что ранние хинолоны (офлоксацин), которые применяются в отношении пневмококков, резистентных к пенициллину, в последнее время показывают рост устойчивости к этому препарату. Для преодоления устойчивости используют новые фторхинолоны с повышенной антипневмококковой активностью: спарфлоксацин, моксифлоксацин и др.
Примерно от 5 до 15% культур пневмококков в России демонстрируют полирезистентные свойств, т. е. одновременной устойчивостью к 3 и более классам препаратов.
Для обнаружение АГ пневмококка в пробах биологических жидкостей пациента применяют методы латекс-агглютинации и ИХА. Наборы реагентов, основанные на реакции латекс-агглютинации или коагглютинации, предназначены для работы с материалом, полученным из стерильных локусов (кровь, ликвор), при работе с нестерильными локусами эти наборы могут давать ложноположительный результат. Чувствительность и специфичность наборов разных производителей составляет 94–100% и 85–98%, соответственно. Набор реагентов с использованием ИХА позволяет определить наличие указанного АГ у больных пневмонией (в моче) и менингитом (в СМЖ). Этот тест рекомендован как дополнительный метод диагностики пневмоний. При исследовании проб пациентов с высоким уровнем назофарингеального носительства возможны ложноположительные результаты.
Для обнаружения специфических генетических фрагментов пневмококка применяют ПЦР, в качестве мишеней используют специфические фрагменты генов, кодирующих факторы патогенности: пневмолизин (Ply), аутолизин (LytA), пневмококковый поверхностный АГ (PsaA), пневмококковый поверхностный протеин А (PspA), марганец-зависимая супероксид-дисмутаза (sodA), поверхностный пенициллин-связывающий белок 2b (Pbp2b), Spn9802, Spn9828. Для повышения специфичности исследования применяется мультиплексная ПЦР, при которой проводится одновременная индикация нескольких генов патогенности с сохранением высокой чувствительности реакции.
Остается проблемой установление диагностически значимых количественных показателей, позволяющих дифференцировать заболевание от носительства при исследовании материала из нестерильных локусов.
Метод исследования продуктов АНК при мультилокусном секвенировании-типировании для генетического типирования пневмококков основан на секвенировании внутренних фрагментов семи генов «домашнего хозяйства» (housekeeping genes), специфичных для возбудителя. Метод чаще используется для генетического типирования пневмококка, чем для идентификации.
Использование метода секвенирования участка 16S рибосомальной РНК для идентификации пневмококков затруднено сходством с некоторыми видами стрептококков, входящих в группу Mitis. Гомология ДНК-ДНК между стрептококками, входящими в группу Mitis, составляет 40–60%, тогда как сходство сиквенсов 16S рРНК генов между S.mitis, S.oralis и S.pneumoniae может достигать более чем 99%. Сравнение участков 16S рРНК между штаммами S.pseudopneumoniae и S.pneumoniae (суммарный размер 1 468 пар нуклеотидов) показало 99,7% совпадение сиквенса, различие отмечено только в 5 парах нуклеотидов.
Для исследования используют также методы РНК-ДНК и ДНК-ДНК гибридизации, в основе которых лежит способность нуклеиновых кислот к гибридизации (TaqMan принцип). Готовый набор реагентов для идентификации «AccuProbe Streptococcus pneumoniae culture identification test» (Gen-Probe, USA) построен на этом принципе с использованием в качестве мишени участка гена 16S рРНК. Для детекции участков рибосомальной РНК исследуемого штамма употребляется одноцепочечная ДНК в качестве зонда, которая комплиментарна выбранной специфичной для пневмококка мишени 16S рРНК и содержит хемолюминесцентную метку. При совпадении нуклеотидов мишени рРНК с нуклеотидами ДНК-зонда образуется устойчивое образование в форме ДНК-РНК гибрида. После добавления селектирующего реагента, дифференцирующего гибридизированные и негиброидизированные пробы, меченые гибриды ДНК-РНК могут быть выявлены с помощью люминометра. Если использовать AccuProbe в качестве референтного стандарта, чувствительность и специфичность бактериологических методов идентификации составляет: для желчного теста 98,8% и 82,6%, для реакции набухания капсулы с Omni сывороткой 99,2 и 74,4%; 87,9 и 59,3% для теста с оптохином.
Обнаружение АТ редко используются при проведении лабораторной диагностики пневмококковой инфекции. Это связано с отсутствием надежных доступных методик, имеющих достаточную чувствительность и специфичность и ролью временного фактора, поскольку для выявления роста титров АТ необходимо значительное время от начала заболевания. В настоящий момент используются определения АТ против четырех АГ пневмококка (С-антигена, капсульных полисахаридов, фосфорилхолина и пневмолизина). Чувствительность метода для С-антигена и капсульных полисахаридов составляет 89% и 97% соответственно. Наиболее распространенные методы определения – ИФА и РИФ (МФА). При применении МФА в качестве АГ рекомендуется использовать аутоштамм пневмококка, выделенный от данного больного. В случае отсутствия аутоштамма применяют смесь штаммов из наиболее часто встречающихся на данной территории серотипов. Выявление минимального диагностического титра АТ к пневмококку у детей до 3 лет 1:320 и 1:640 у взрослых свидетельствует о пневмококковой этиологии перенесенного заболевания.
Пневмококковая инфекция
Информацию из данного раздела нельзя использовать для самодиагностики и самолечения. В случае боли или иного обострения заболевания диагностические исследования должен назначать только лечащий врач. Для постановки диагноза и правильного назначения лечения следует обращаться к Вашему лечащему врачу.
Пневмококковая инфекция: причины появления, симптомы, диагностика и способы лечения.
Определение
Пневмококковую инфекцию вызывают пневмококки – бактерией Streptococcus pneumoniae. Причем источником инфекции может быть только человек – больной или бактерионоситель. До начала широкого применения антибиотиков пневмококк считался причиной 95% случаев пневмонии, а до появления профилактических прививок эта инфекция ежегодно уносила жизни 1,6 млн человек, из которых до 1 млн составляли дети.
И хотя успехи в борьбе с пневмококковой инфекцией можно назвать впечатляющими, по мнению специалистов ВОЗ, до сих пор до 35% случаев внебольничной пневмонии в мире обусловлено S. pneumoniae, а в развивающихся странах пневмококк каждый год убивает почти полмиллиона детей младше пяти лет.
Распространенность пневмококковой инфекции составляет от 10 до 100 случаев на 100 тысяч населения в год.
Причины возникновения пневмококковой инфекции
Известно 96 серотипов (разновидностей) пневмококка, различающихся по способности вызывать заболевание, однако около 90% инфекций вызывают бактерии 20-25 наиболее распространенных серотипов. В разных географических регионах за инфекцию в популяции ответственны разные серотипы, и этот так называемый серотиповой состав может меняться со временем. Основной резервуар инфекции в человеческой популяции – дети до 5 лет, которые очень часто являются бессимптомными носителями (пребывание пневмококка в носоглотке ребенка не сопровождается болезненными проявлениями). Длительность вирусоносительства колеблется от 2–3 недель до 3–4 месяцев.
Заразиться пневмококком можно от больного человека или носителя при чихании и кашле. Попадая на слизистую оболочку верхних дыхательных путей, S. pneumoniae начинает размножаться. О распространении инфекции свидетельствует развитие местных форм инфекции (отита, синусита, бронхита, пневмонии) или генерализованной формы (пневмонии с бактериемией, менингита или сепсиса), если микроорганизму удалось проникнуть в кровеносное русло.
В группе высокого риска летального исхода находятся в первую очередь дети младше 2 лет и взрослые старше 65 лет. Инфекция протекает крайне тяжело на фоне сопутствующих заболеваний – хронических бронхообструктивных заболеваний легких, патологий сердечно-сосудистой системы (ИБС, сердечной недостаточности, кардиомиопатии, хронической сердечной недостаточности), онкогематологических заболеваний, при сахарном диабете и ожирении, болезнях почек и печени, после удаления селезенки, при иммунодефицитных состояниях, в т.ч. ВИЧ.
По статистике, риск развития инвазивных форм пневомококковой инфекции увеличивается при бронхиальной астме в 2 раза, хронической обструктивной болезни легких – в 4 раза, легочном фиброзе – в 5 раз, саркоидозе и бронхоэктазах – в 2–7 раз.
Установлена прямая связь частоты возникновения инвазивных форм пневомококковой инфекции с возрастом, курением и лечением системными или ингаляционными глюкокортикостероидами.
Среди новорожденных риск тяжелого течения выше у детей, находящихся на искусственном вскармливании и с нарушениями пищеварения.
Вспышки пневмококковой инфекции часто возникают в закрытых коллективах: в детских садах, школах, домах ребенка, общежитиях, тюрьмах, домах престарелых и т.д., где, кстати, выявляется и наиболее высокий уровень носительства пневмококка.
Быстрое распространение респираторных заболеваний и более тяжелое их течение отмечается у работников промышленных предприятий, где производство связано с контактом с парами металлов, минеральной или любой другой пылью или газообразными веществами.
Классификация заболевания
Выделяют инвазивные и неинвазивные формы пневмококковых заболеваний. Инвазивная пневмококковая инфекция диагностируется на основании выделения пневмококка или его ДНК из исходно стерильных органов и тканей и представляет собой целый ряд тяжелых и угрожающих жизни заболеваний: бактериемию без видимого очага инфекции, менингит, пневмонию, сепсис, перикардит, артрит.
К неинвазивным формам инфекции относятся бронхит, внебольничная пневмония, отит, синусит, конъюнктивит.
Симптомы пневмококковой инфекции
Инкубационный период составляет от 1 до 3 дней. Болезнь может проявляться в виде воспаления легких (пневмококковая пневмония), воспаления мягкой мозговой оболочки (пневмококковый менингит), воспаления среднего уха (пневмококковый отит) и слизистой оболочки околоносовых пазух и полости носа (синусит), а также в виде пневмококкового сепсиса – заражения крови.
Пневмококковый менингит всегда начинается остро – температура повышается до 40оС, пациенты жалуются на нестерпимую разлитую головную боль, к которой присоединяется рвота и светобоязнь. Выявляются также общемозговые симптомы: помимо головной боли, тошноты и рвоты появляются стопор и кома. У некоторых больных на груди, руках и ногах появляется геморрагическая сыпь. К специфическим симптомам менингита (менингеальным симптомам) относятся:
- ригидность мышц затылка (рефлекторное повышение тонуса мышц, при котором пациент не в состоянии наклонить голову);
- симптом Кернига (врач не может разогнуть ногу больного в коленном суставе, если она согнута под прямым углом в тазобедренном и коленном суставах, поскольку мешает напряжение задней группы мышц бедра (тонический оболочный рефлекс));
- симптом Брудзинского (при пассивном наклоне головы вперед происходит автоматическое сгибание нижних конечностей в тазобедренных и коленных суставах и подтягивание их к животу).
Пневмококковый острый средний отит чаще всего диагностируется у детей до 2 лет. У больных повышается температура, наблюдается заложенность и сильная боль в ухе, которая может иррадиировать в шею, челюсть, область глаз, повышается чувствительность к звукам, нарушается равновесие.
При попадании инфекции в кровь возникает системное воспаление – сепсис с характерным токсическим шоком.
На сепсис могут указывать повышенная или пониженная температура тела, учащенные сердцебиение и дыхание, сниженное артериальное давление. У больного отмечаются рвота, спутанностью сознания, присоединяются симптомы поражения других органов и систем (сердца, кишечника, почек, легких, мозга). Пневмококковый сепсис – это жизнеугрожающее состояние.
Диагностика пневмококковой инфекции
Диагностика инвазивной пневмококковой инфекции основывается на выделении пневмококка из стерильных жидкостей организма (спинномозговой жидкости, крови), для определения неинвазивной пневмококковой инфекции могут использоваться и другие среды – мокрота, жидкость из полости среднего уха и др.
Микроскопическое исследование позволяет получить предварительный результат. Далее бактерии культивируют на питательных средах. Широкое и бесконтрольное использование антибактериальных препаратов пациентами до обращения за медицинской помощью приводит к возрастанию резистентности (устойчивости) пневмококков к антибиотикам, поэтому для назначения адекватной терапии до начала лечения определяют чувствительность выделенного микроорганизма к антибиотикам.
Часто в лабораторной диагностике применяют ПЦР-тестирование (определение ДНК микроорганизма в крови, мокроте, слюне, соскобе эпителиальных клеток ротоглотки), которое обладает высокой чувствительностью, быстротой получения результата и возможностью проведения анализа после начала антибактериальной терапии.
В последние годы все чаще применяют иммунохроматографический экспресс-тест для выявления пневмококкового клеточного полисахарида (С-полисахарида) в моче. Этот тест адаптирован только для образцов мочи взрослых пациентов и применяется до начала антибактериальной терапии.Диагностические мероприятия также включают:
- общий анализ крови;
Из инструментальных методов назначают:
- рентгенографию органов грудной клетки (при пневмонии);
Лечением пневмококковой инфекции занимаются врачи-пульмонологи и инфекционисты.
Лечение пневмококковой инфекции
Главной проблемой в лечении пневмококковой инфекции является устойчивость бактерий к антибиотикам. По современным данным, процент устойчивых пневмококков минимум к одному антибактериальному препарату достигает 25-30%. Поэтому до начала лечения определяют перечень антибиотиков, к которым чувствителен выделенный в лабораторных условиях микроорганизм.
Симптоматическая терапия пневмококковой инфекции:
- препараты для разжижения мокроты и облегчения ее выведения;
- жаропонижающие средства;
- противовоспалительные и обезболивающие препараты;
- дезинтоксикационная терапия;
- пре- и пробиотики.
Пневмококковые инфекции чреваты серьезными осложнениями, в том числе жизнеугорожающими.
- эмпиема легких – скопление гноя в плевральной полости, вызывающее уменьшение дыхательной поверхности легочной ткани и приводящее к летальному исходу (до 2/3 случаев);
- абсцесс легкого;
- сердечная недостаточность;
- дыхательная недостаточность.
- эпилепсия;
- задержка умственного развития;
- потеря слуха или глухота.
- перфорация барабанной перепонки;
- мастоидит (воспаление сосцевидного отростка височной кости);
- менингит и абсцесс головного мозга.
- тромбоз сосудов головного мозга;
- менингит;
- конъюнктивит;
- неврит зрительного нерва.
Попадание бактерий в кровь (бактериемия) может вызвать поражения суставов, околосердечной сумки, отказ внутренних органов и сопровождается высокой летальностью.
Профилактика пневмококковой инфекции
Единственный надежный способ профилактики – вакцинация от пневмококковой инфекции (в 2013 году вакцину от пневмококка включили в Российский Национальный календарь профилактических прививок).
Типы пневмококковых вакцин:
- Превенар 13 (США) – защищает от 13 самых распространенных серотипов пневмококка. Эту вакцину применяют у новорожденных, начиная с 2 месяцев. Российский Национальный календарь рекомендует вводить эту вакцину в 2, 4, 6 месяцев и далее ревакцинировать ребенка в возрасте 12-15 месяцев.
- Клинические рекомендации «Внебольничная пневмония у взрослых». Разраб.: Российское респираторное общество, Межрегиональная ассоциация по клинической микробиологии и антимикробной химиотерапии. – 2021.
- Клинические рекомендации «Пневмония (внебольничная)». Дети. Разраб.: Союз педиатров России, Межрегиональная ассоциация по клинической микробиологии и антимикробной химиотерапии. – 2022.
- Чучалин А.Г., Брико Н.И., Авдеев С.Н., Белевский А.С., Биличенко Т.Н., Демко И.В., Драпкина О.М., Жестков А.В., Зайцев А.А., Игнатова Г.Л., Ковалишена О.В., Коршунов В.А., Костинов М.П., Мишланов В.Ю., Сидоренко С.В., Трушенко Н.В., Шубин И.В., Фельдблюм И.В. Федеральные клинические рекомендации по вакцинопрофилактике пневмококковой инфекции у взрослых. Пульмонология. 2019; 29 (1): 19–34.
- Диагностика пневмококковых инфекций респираторного тракта А.З. Зарипова, Р.И. Валиева, Л.Т. Баязитова, М.В. Целищева // Практическая пульмонология. – 2018. – № 4. – С 74-80.
Микробиологическая диагностика пневмококка. Диагностика пневмококковой инфекции. Выявление пневмококка. Выделение пневмококка. Лечение пневмококковой инфекции.
Инфекция вызванная пневмококком (Streptococcus pneumoniae): диагностика, лечение, профилактика
Streptococcus pneumoniae (пневмококк) — грамположительный кокк, который при росте на питательных средах образует ланцетовидные пары. Чувствителен к оптохину, подвержен лизису в присутствии солей жёлчи.
При росте на кровяном агаре штаммы пневмококка обычно обладают частичным гемолизом (а-гемолиз), в то же время гемолитическая активность различных штаммов может меняться. Инфекционные заболевания, вызванные пневмококком, — одна из самых распространённых причин смерти пациентов во всём мире. В группу риска входят дети, пожилые пациенты, а также лица с сопутствующими заболеваниями.
Патогенез пневмококковой инфекции (Streptococcus pneumoniae)
Пневмококки окружены полисахаридной капсулой, препятствующей фагоцитозу. Существует более девяноста различных капсульных серотипов возбудителя с различным уровнем патогенности и способностью к инвазии. Полисахарид, входящий в состав капсулы, обладает выраженными антигенными свойствами.
Антитела к капсульным полисахаридам у различных серотипов пневмококка — протективные, в то же время возможны перекрёстные иммунные реакции между различными серотипами. Компоненты клеточной стенки микроорганизма также способны вызывать выраженный воспалительный процесс.
Кроме того, пневмококки имеют несколько факторов адгезии, способствующих прикреплению возбудителя к полисахаридам поверхности клеток, что способствует колонизации организма.
![пневмококковая инфекция]()
Колонизация пневмококковой инфекции (Streptococcus pneumoniae)
Единственный источник инфекции — человек; носительство обычно протекает бессимптомно. Распределение серотипов зависит от региона, возраста пациента и социальной группы. Наиболее подвержены острой пневмонии дети первого года жизни.
Факторы, предрасполагающие к развитию тяжёлой инфекции: недостаточность комплемента, агаммаглобулинемия, ВИЧ-инфекция, алкоголизм и спленэктомия (удаление селезёнки). Немаловажную роль в развитии инфекционного процесса играют пневмококковые токсины: пневмолизин, нейраминидаза, гиалуронидаза и адгезины (например, пневмококковый поверхностный белок типа А).
Бактерии способны прикрепляться к пневмоцитам и проникать в кровоток, связываясь с рецепторами фактора агрегации тромбоцитов и активируя выработку пневмолизина или комплемент-индуцированного повреждения альвеол.
Клинические признаки инфекции вызванной пневмококком (Streptococcus pneumoniae)
Чаще всего Streptococcus pneumoniae вызывает острые отиты, синуситы и пневмонию. В 50—70% случаев причиной возникновения внебольничной пневмонии становятся пневмококки, при этом у 25—30% пациентов развивается бактериемия.
Прямое или гематогенное распространение инфекции приводит к развитию менингита и реже к целлюлиту, абсцессам, перитониту и эндокардиту. Бактериемия — тяжелейшее осложнение пневмококковой инфекции с высокой летальностью даже при соответствующем лечении.
Пневмококк считают второй из наиболее распространённых причин развития внебольничного менингита у детей, вакци-низированных против Haemophilus influenzae типа В, и основной причиной менингита у пациентов старше сорока лет. При этом отмечают достаточно высокий уровень смертности и вероятности развития осложнений.
![пневмококковая инфекция]()
Чувствительность пневмококка (Streptococcus pneumoniae) к антибиотикам
Ранее при лечении пневмококковых инфекций самым эффективным препаратом был пенициллин, но позднее благодаря генетической модификации пенициллинсвязывающего белка большинство штаммов приобрело к нему устойчивость. В настоящее время в клинической практике используют эритромицин, цефалоспорины, тетрациклин, рифампицин и хлорамфеникол, но всё чаще сталкиваются с мультирезистентными штаммами.
Препаратом выбора продолжает оставаться пенициллин, а при менингите, вызванном менее чувствительными штаммами, применяют цефотаксим или цефтриаксон. В случае высокой устойчивости к пенициллину дополнительно назначают гликопептидные препараты (ванкомицин).
Профилактика заболевания вызванной пневмококком (Streptococcus pneumoniae)
Для профилактики пневмококковой инфекции применяют поливалентную капсульную полисахаридную вакцину для профилактики пневмококковых инфекций, эффективную при назначении пациентам в зрелом возрасте и менее действенную у лиц со сниженным иммунитетом и детей младше двух лет.
Недавно созданная конъюгированная вакцина обладает достаточно высокой иммуностимулирующей способностью у детей младшего возраста.
Редактор: Искандер Милевски. Дата обновления публикации: 18.3.2021
- Вернуться в раздел "Микробиология"
Информация на сайте подлежит консультации лечащим врачом и не заменяет очной консультации с ним.
См. подробнее в пользовательском соглашении.Часто в лабораторной диагностике применяют ПЦР-тестирование (определение ДНК микроорганизма в крови, мокроте, слюне, соскобе эпителиальных клеток ротоглотки), которое обладает высокой чувствительностью, быстротой получения результата и возможностью проведения анализа после начала антибактериальной терапии.
Определение ДНК Streptococcus pneumoniae в плазме крови методом ПЦР с детекцией в режиме реального времени. Пневмококк Streptococcus pneumoniae относится к роду стрептококков. S. pneumoniae.
Читайте также: